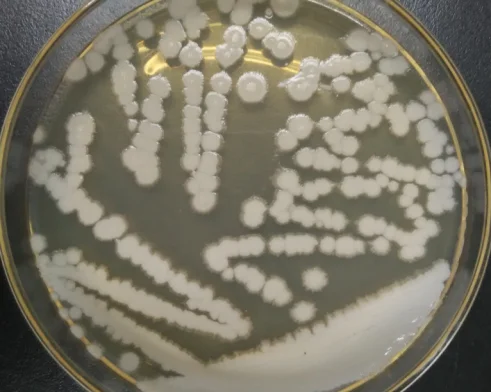
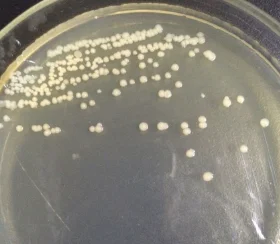
High viable count  probiotic Bacillus licheniformis powder with competitive price for animal feed

High viable count probiotic Bacillus licheniformis powder with competitive price for animal feed
- Category: >>>
- Supplier: Shandong Baolai-Leelai Bio-Tech Co. Ltd.
Share on (1600207192709):
Product Overview
Description
Product ingredients:

≥10 Billion cfu/g
Function and Advantage
⑴ Antagonistic animal pathogens and maintain and adjust the balance of gastrointestinal microecology
a variety of antimicrobial substances can be produced in the growth and metabolism process, and it has a strong antagonistic effect on Staphylococcus and Candida albicans.Enter the intestines and stomach can quickly planting and breeding, oxygen consumption, forming a low oxygen environment, to the intestinal tract of physiologic anaerobic bacteria such as bifidobacterium, lactobacillus, digestion and streptococcus beneficial microorganisms grow create favorable conditions, so as to inhibit the growth of harmful bacteria, to adjust the dysbacteriosis, make intestines and stomach function was restored.

[2] to produce a variety of enzymes and improve animal digestive enzyme activity:
bacillus licheniformis can produce many kinds of active enzyme, such as protease, amylase and lipase, pectinase, glucanase, cellulase and so on, at the same time also can produce a variety of enzymatic factor, enhance the animal digestive enzyme activity, promote the growth of farmed animals, improve the feed utilization rate.

⑶ Enhance the immune function of the animal body:
It can enhance the specific and non-specific immune response of the body, promote the phagocytic activity of macrophages, and improve the ability of anti-infection.
Certifications

Company Profile






Baolai-Leelai Bio-industrial Group ,a national high-tech enterprise ,was established in 1996 and is the largest supplier of immune micro-ecology preparation products and solution service provider in China. The group has four wholly-owned subsidiaries and 34 sets of GMP standard fermentation equipments, with a total investment of more than 7 million USD and a P3 laboratory, and the annual production capacity of 1,000 tons of probiotic powder . The company integrates global micro-ecological research and development resources, and has conducted in-depth cooperation and research and development with Harvard University, Yale University, Free University of Berlin and others. So far ,with our products exported to more than 30 countries including the European Union, North America, South America, Southeast Asia, and Africa , we are always looking forward to establishing a win-win cooperative relationship with you in the future.
FAQ
1. who are we?
We are based in Shandong, China, start from 1996,sell to Domestic Market.
2. how can we guarantee quality?
Always a pre-production sample before mass production;
Always final Inspection before shipment;
3.what can you buy from us?
Human probiotic,Animal probiotic,Feed additive,Health care,Compound probiotic
4. why should you buy from us not from other suppliers?
Our company was founded in 1996,we have 24 years R&D experience and P3 laboratory,we are professional in probiotics animal feed additives and human healthcare supplement,devoted to ecological breeding and food safety,OEM and ODM service are provided.
5. what services can we provide?
Accepted Delivery Terms: FOB,CFR,CIF,EXW,Express Delivery,DAF;
Accepted Payment Currency:USD,EUR;
Accepted Payment Type: T/T,L/C,MoneyGram,Credit Card,PayPal,Western Union,Cash;
Language Spoken:English,Spanish,Portuguese,Russian
We are based in Shandong, China, start from 1996,sell to Domestic Market.
2. how can we guarantee quality?
Always a pre-production sample before mass production;
Always final Inspection before shipment;
3.what can you buy from us?
Human probiotic,Animal probiotic,Feed additive,Health care,Compound probiotic
4. why should you buy from us not from other suppliers?
Our company was founded in 1996,we have 24 years R&D experience and P3 laboratory,we are professional in probiotics animal feed additives and human healthcare supplement,devoted to ecological breeding and food safety,OEM and ODM service are provided.
5. what services can we provide?
Accepted Delivery Terms: FOB,CFR,CIF,EXW,Express Delivery,DAF;
Accepted Payment Currency:USD,EUR;
Accepted Payment Type: T/T,L/C,MoneyGram,Credit Card,PayPal,Western Union,Cash;
Language Spoken:English,Spanish,Portuguese,Russian
We Recommend
New Arrivals
New products from manufacturers at wholesale prices